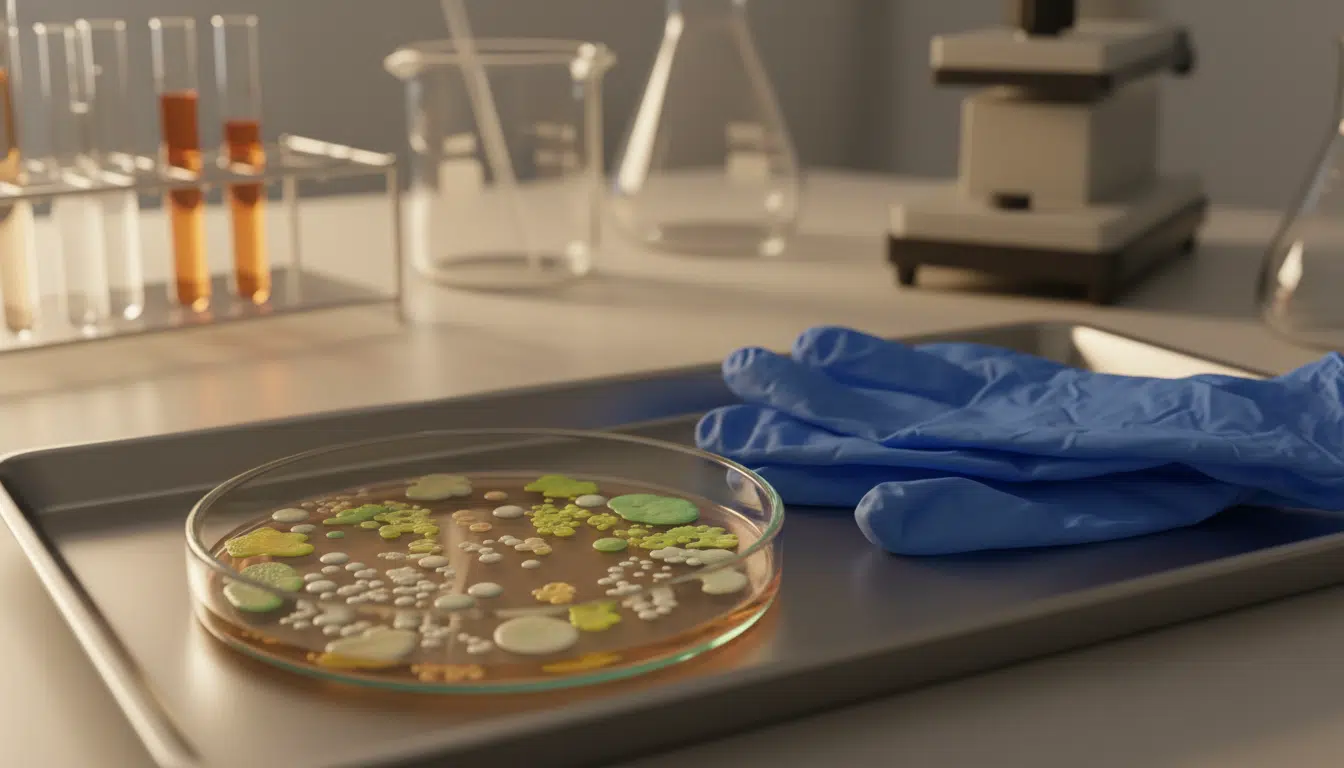
Boîte de Petri avec colonies de bactéries en laboratoire

Ces 7 plats Carrefour Le Marché contaminés à la listeria : la liste complète
Sept salades et plats préparés vendus dans tous les magasins Carrefour de France viennent d’être retirés de la vente. En cause : une suspicion de contamination à la listeria, cette bactérie responsable de la listériose. Si vous avez fait vos courses entre le 30 mars et le 3 avril, vérifiez votre réfrigérateur sans attendre.
Salade niçoise, penne carbonara, poulet tikka masala… les produits concernés
Le site officiel Rappel Conso a publié simultanément plusieurs fiches d’alerte visant des références de la gamme Carrefour Le Marché. La liste est précise : une salade niçoise, des penne arrabbiata et thon, des penne carbonara, une salade à l’italienne, une salade César, un porc au caramel et un poulet tikka masala.
Ces sept produits ont tous été commercialisés entre le 30 mars et le 3 avril 2025 dans l’ensemble des magasins Carrefour du territoire français. Ce n’est pas la première fois que l’enseigne est visée : récemment, une viande Carrefour avait également fait l’objet d’un retrait. Les numéros d’identification des lots figurent sur les fiches détaillées de Rappel Conso, à consulter pour vérifier les références exactes présentes dans votre frigo.
La listeria, une bactérie qui ne prévient pas toujours
La contamination suspectée implique la bactérie Listeria monocytogenes, un micro-organisme redoutable qui prolifère même à basse température, y compris dans un réfrigérateur bien réglé. Contrairement à d’autres intoxications alimentaires dont les symptômes apparaissent en quelques heures, la listériose joue la carte de la discrétion. Son délai d’incubation peut atteindre huit semaines, ce qui complique considérablement le lien entre la consommation et les premiers signes.
Les symptômes les plus fréquents sont une fièvre isolée, parfois accompagnée de maux de tête et de courbatures. À ce stade, beaucoup pensent à une simple grippe. Pourtant, dans ses formes graves, la maladie peut provoquer des complications neurologiques sévères : méningites, encéphalites, septicémies. Le danger est réel, comme l’ont tristement rappelé deux décès liés à la listériose survenus en France il y a peu.

Femmes enceintes et personnes âgées : vigilance maximale
Rappel Conso insiste sur trois catégories de population particulièrement vulnérables face à cette bactérie. Les femmes enceintes courent un risque d’atteintes maternelles ou fœtales pouvant aller jusqu’à la fausse couche ou l’accouchement prématuré. Les personnes immunodéprimées — sous traitement lourd, greffées, atteintes d’un cancer — sont également en première ligne.
Quant aux personnes âgées, leur système immunitaire moins réactif les expose davantage aux formes graves de la maladie. Si vous appartenez à l’une de ces catégories et que vous avez consommé l’un de ces plats, consultez votre médecin traitant sans tarder, même en l’absence de symptômes immédiats. Précisez-lui la consommation du produit concerné : cette information est essentielle pour le diagnostic.
Que faire si vous avez ce produit chez vous ?
La marche à suivre est simple. Ouvrez votre réfrigérateur et vérifiez si l’un de ces sept plats préparés Carrefour Le Marché s’y trouve. Si c’est le cas, deux options : rapporter le produit en magasin pour obtenir un remboursement, ou le détruire directement. Dans tous les cas, ne le consommez surtout pas, même si la date de péremption n’est pas dépassée.
À lire aussi
La procédure de rappel court jusqu’au mardi 21 avril 2025. Passé cette date, il ne sera plus possible de demander un remboursement en point de vente. Pour retrouver les références exactes et les numéros de lot de chaque produit, rendez-vous directement sur le site de Rappel Conso, le portail officiel géré par les autorités sanitaires.
Les rappels alimentaires se multiplient en France
Ce rappel massif s’inscrit dans une tendance préoccupante. Ces derniers mois, les alertes sanitaires se sont enchaînées dans la grande distribution française. Chez Lidl, une salade de pâtes avait été retirée pour le même motif. Des millions d’œufs contaminés ont également été rappelés, tout comme des fromages chez Intermarché et U.
La listeria est impliquée dans une part significative de ces alertes. Un rappel massif de fromages avait causé 21 cas de listériose, dont 2 décès, et un jambon blanc chez Intermarché a récemment été épinglé pour la même raison. Même constat pour un fromage Lidl retiré pour contamination microbiologique.
Comment limiter les risques au quotidien
Au-delà de ce rappel spécifique, quelques réflexes permettent de réduire l’exposition à la listeria. Conservez vos plats préparés à une température inférieure à 4 °C et respectez scrupuleusement les dates limites de consommation. La bactérie se développe lentement au froid, mais elle se développe quand même.
Nettoyez régulièrement votre réfrigérateur, notamment les compartiments où vous stockez des produits frais emballés. Un geste simple — une pièce dans le congélateur avant de partir en vacances — peut aussi vous alerter sur une éventuelle rupture de la chaîne du froid pendant votre absence. Les aliments ultra-transformés posent par ailleurs d’autres questions sanitaires qu’il est bon de garder en tête.
Enfin, consultez régulièrement le site Rappel Conso. L’application mobile permet aussi de recevoir des notifications en temps réel. Dans un contexte où les alertes alimentaires deviennent quasi hebdomadaires, cette habitude peut éviter bien des soucis — pour vous comme pour vos proches.
